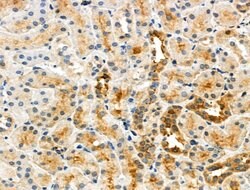
Invitrogen Phospho-Caspase 3 (Ser26) Polyclonal Antibody 100 &mu;L; Unconjugated:Antibodies,

missing translation for 'onlineSavingsMsg'
Learn More
Learn More
Invitrogen™ Phospho-Caspase 3 (Ser26) Polyclonal Antibody


Rabbit Polyclonal Antibody
Brand: Invitrogen™ PA5118735
This item is not returnable.
View return policy
Description
Antibody detects endogenous levels of Caspase 3 only when phosphorylated at Ser26.
This gene encodes a protein which is a member of the cysteine-aspartic acid protease (caspase) family. Sequential activation of caspases plays a central role in the execution-phase of cell apoptosis. Caspases exist as inactive proenzymes which undergo proteolytic processing at conserved aspartic residues to produce two subunits, large and small, that dimerize to form the active enzyme. This protein cleaves and activates caspases 6, 7 and 9, and the protein itself is processed by caspases 8, 9 and 10. It is the predominant caspase involved in the cleavage of amyloid-beta 4A precursor protein, which is associated with neuronal death in Alzheimer's disease. Alternative splicing of this gene results in two transcript variants that encode the same protein.
Specifications
| Phospho-Caspase 3 (Ser26) | |
| Polyclonal | |
| Unconjugated | |
| CASP3 | |
| A830040C14Rik; AC-3; Apopain; Apopain precursor; Casp3; CASP-3; caspase 3; Caspase 3 apoptosis related cysteine protease (ICE-like cysteine protease); caspase 3, apoptosis related cysteine protease; Caspase 3, apoptosis related cysteine protease (ICE-like cysteine protease); caspase 3, apoptosis-related cysteine peptidase; caspase 3, apoptosis-related cysteine protease; Caspase3; caspase-3; Caspase-3 subunit p12; Caspase-3 subunit p17; Caspase-3-like protein; CC3; Cpp32; CPP-32; CPP32B; CPP32beta; cysteine protease CPP32; cysteine protease; CPP32; apopain; ICE3; IRP; LICE; mldy; PARP cleavage protease; procaspase3; protein Yama; SCA-1; SREBP cleavage activity 1; Yama; yama protein | |
| Rabbit | |
| Sequential Chromatography | |
| RUO | |
| 12367, 25402, 836 | |
| -20°C | |
| Liquid |
| Immunohistochemistry (Paraffin), Western Blot, Immunocytochemistry | |
| 1 mg/mL | |
| PBS with 50% glycerol and 0.02% sodium azide; pH 7.4 | |
| P42574, P55213, P70677 | |
| CASP3 | |
| A synthesized peptide derived from human CASP3(Accession P42574), corresponding to amino acid residues around phosphorylated Ser26. | |
| 100 μL | |
| Primary | |
| Human, Mouse, Rat | |
| Antibody | |
| IgG |
Product Content Correction
Your input is important to us. Please complete this form to provide feedback related to the content on this product.
Product Title
Spot an opportunity for improvement?Share a Content Correction